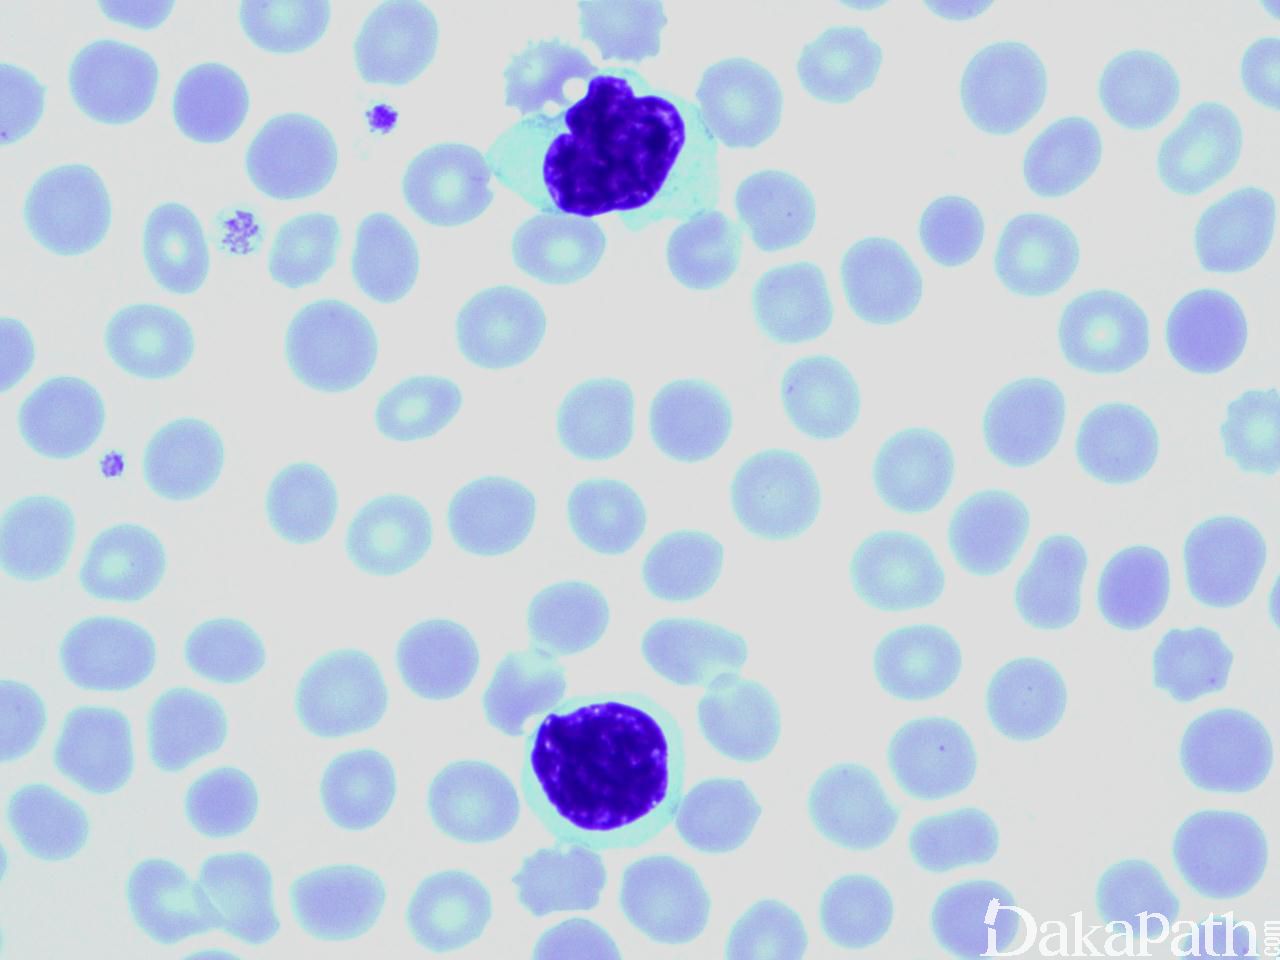

Sezary 综合症
Sezary Syndrome, SS
概述:
SS 特征包括红皮病、全身淋巴结肿大和外周血中循环的具脑回样核的肿瘤 T 细胞(Sezary 细胞),Sezary 细胞计数 ≥1000/mm3. CD4/CD8 比例明显升高(≥10)及免疫表型异常。SS 与 MF 密切相关,但二者被认为是不同的疾病实体。不少 SS 患者没有明显 MF 病史。
诊断要点:
- 少见,占所有皮肤 T 细胞淋巴瘤不到 5%。主要见于中老年,男性较多。SS 是系统系统性疾病,肿瘤侵犯外周血、皮肤、淋巴结和内脏。表现为弥漫性皮肤红斑、手掌和脚掌过度角化和全身淋巴结肿大。不少患者没有明显 MF 病史。
- 外周血大量循坏异形淋巴细胞,脑回样核,细胞大小因病例而定,肿瘤细胞计数 ≥1000/ mm3。皮肤病理形态与 MF 相似,但侵润细胞更具单形性,亲表皮可以不明显,少数病例皮肤无特异性改变。淋巴结结构部分或全破坏,被肿瘤细胞取代。骨髓侵犯不明显,仅见希少间质侵润。
- 免疫表型/流式:肿瘤细胞 CD3+、CD4+、CD8-、CD26-、CD7-、CD4/CD8≥10. CD4+/CD7-(>30%)、CD4+/CD26-(>40%)
- TCR 基因克隆性重排。常有复杂染色体异常(数量和结构改变)及基因突变。
鉴别诊断:
- 反应性红皮病 :不累及淋巴结和内脏,外周血可见少量小型脑回样核淋巴细胞,但无克隆性 TCR 基因重排,有相应临床病史(如用药史)。
- T 细胞幼淋细胞白血病 (T-PLL):侵犯外周血、淋巴结、肝脾和皮肤(少数病例)。外周血淋巴细胞显著增高,肿瘤细胞中等大小,含明显中央核仁,少数小细胞型可有脑回样核。免疫表型 CD3+、CD7+、TCL-1+、CD26+。皮肤表现为血管周围或真皮弥漫浸润。
- 成人 T 细胞白血病/淋巴瘤 (ATLL):根据不同临床变异型,可侵犯外周血(表现为白血病)、淋巴结和皮肤。患者携带 HTLV-1,血清检查阳性。淋巴细胞异形分叶(花细胞),表达 CD3. CD25,通常不表达 CD7。常有高血钙症。
预后:
临床过程为侵袭性。中位生存期 32 个月,5 年存活率 10-30%。